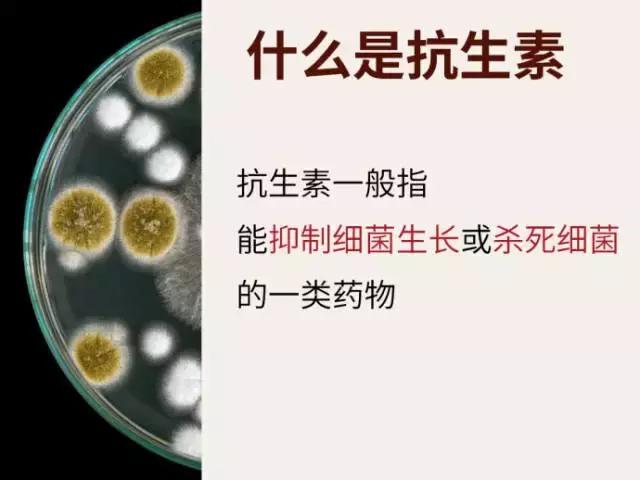
他用了抗生素，肺部烂成“棉花状”！抗生素到底是救人还是杀人？

我感冒了,吃什么药好得快?
基本上10个人里面有9个人会回答你:“吃点感冒药和消炎药,很快就会好~”
说到消炎药,就是阿莫西林、阿莫西林、阿莫西林……?阿莫西林已经这么深入人心了么?你真的知道阿莫西林是个什么玩意?

今年7月,李先生前往武汉市第三医院就诊。他表示,自己已经咳嗽了两个多星期,且中途也在服用阿莫西林及其他抗生素,但并未好转。
医生拍片检查后惊讶地发现,李先生的肺已经成了“棉花状”,属于霉菌感染。
经询问后得知,半年以来,李先生只要一咳嗽就前往小药店购买抗生素吃,一次就吃2个星期左右。一开始使用的还是第三类头孢类抗生素这种“高级药”,不知道是无良的药店给他推销的,还是李先生自行购买服用。
医生告知李先生:这就是滥用抗生素的后果。一些本可通过吃消炎药治疗的病症,李先生却选择了抗生素,导致出现这种结果。
并非所有病症都可以通过抗生素治疗,而长期服用抗生素,不仅会出现耐药性,会使人体内的菌落群体严重失调,导致人体一系列不良反应,甚至可能使霉菌大量繁殖,出现感染症状甚至危害人体生命。

先来科普一下「抗生素」和「消炎药」的区别:

简单来说:
抗生素是用来抑制或杀死细菌的药品;
消炎药是用来减轻炎症的药品,在医学上叫解热镇痛药或者解热镇痛抗炎药;
「抗生素」和「消炎药」哪里不同?
简单来说,细菌感染可以引起炎症,但是炎症不一定都是由感染引起的,感染和非感染的因素都可以引起炎症。
所以说,这两种药并不对等,面对由病毒感染的炎症,抗生素无效。举个最普通的例子吧,人人都得过感冒,致病因素是病毒或者细菌,而抗生素只对细菌性感冒有用,它可以杀死致病细菌从而达到治疗的目的,但其实大部分感冒都是由于病毒引起的,选择多喝水可以自行痊愈或者感冒冲剂等药品也能抑制病毒达到治疗效果,那为什么要选择抗生素?
哪些属于抗生素?

什么情况下一般不使用抗生素?

1、感冒。由于90%的感冒都是由于病毒引起的,所以抗生素起不到治疗作用,即使是病毒+细菌引起的感冒,医生给你开了抗生素吃,下一次还出现相同症状时,这次的抗生素也可能起不到作用了。
2、慢性咽炎。慢性咽炎一般没有病菌,不推荐抗生素。
3、妇科炎症。只有急性炎症发作才可能使用抗生素,并且必须是医院进行过细菌培养和药敏试验后选用的药品。一般的慢性盆腔炎、慢性子宫颈炎不需要抗生素。
4、前列腺炎。只有约5%—10%的前列腺炎是明确的细菌感染,需要使用抗生素,请不要觉得自己有炎症不舒服擅自使用抗生素!
5、非感染性腹泻。由于病毒引起的寒湿型腹泻、暴饮暴食引起的伤食型腹泻、以及脾虚腹泻,都不推荐用抗生素。
6、腮腺炎。腮腺炎好发于青少年,它是由于病毒入侵引起炎症,所以一般抗生素无效。
7、鼻窦炎。鼻窦炎可能由细菌或病毒引起,患者无法判断时应遵循医生的意见选择用药。
8、胃炎。有些胃炎是细菌性感染,比如幽门螺杆菌,但这种病菌比较顽固,它并不能靠一般的抗生素清除。至于由于自身饮食习惯不好导致的胃炎,抗生素更无法起到效果。请在医生点拨下选择用药。
滥用抗生素的危害

用通俗的话来解释,假设人体内是一个场地,人体体内本身存在一些“和谐稳定”的菌落,一颗抗生素吞下来,不小心把这个菌落的A杀死一些,不小心把那个菌落的B又杀死一些,或者把某个菌落全灭,很容易导致这些菌落的“其他菌”不满顺势*反造**,产生一些斗争,可最终伤害的却是人体这个“战争场地”。

而当下次这颗抗生素再来捣乱时,这些菌落早就已经吸取前菌教训做好了防护措施,以至于抗生素无法再杀死这些菌落,导致抗生素失效。

滥用抗生素的危害,也不用我过多赘述了,只要大家记住,抗生素虽然很神奇,但并不是万能药,他的治疗效果也是有针对性的,在面对某些细菌感染时它会是个得力的伙伴,但在对抗其他强敌时,它便会毫无用武之地。请谨慎用药,对自己负责!